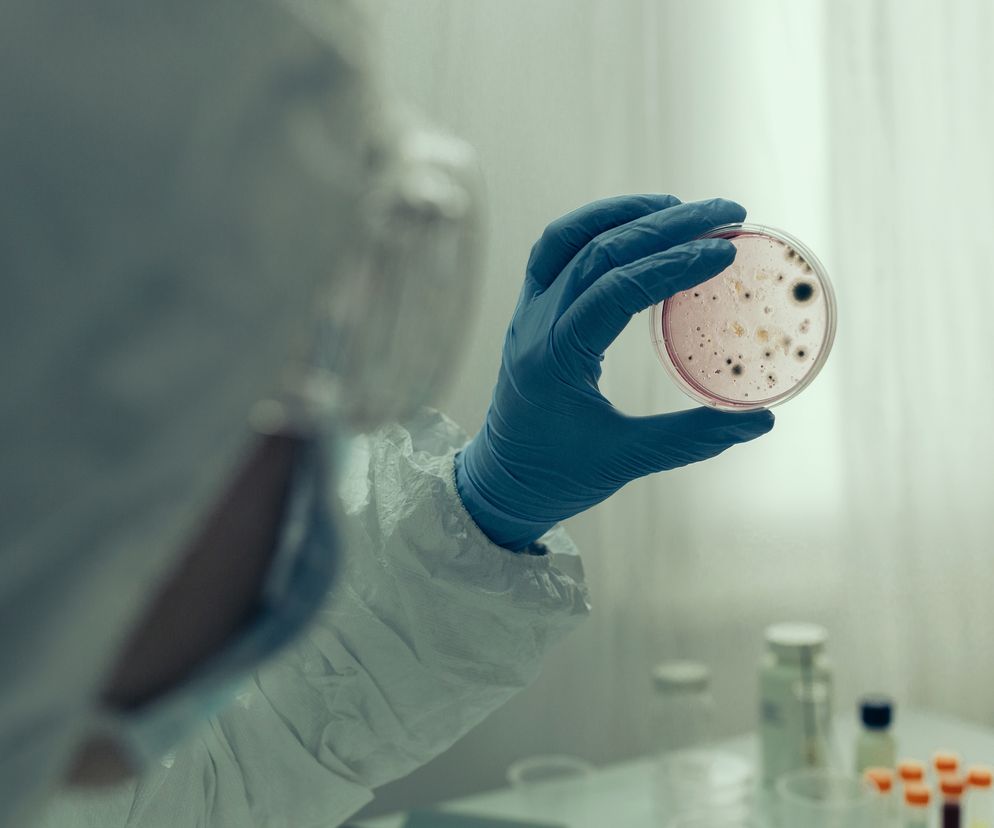
Naukowiec bada próbki w laboratorium

Zespół z Brigham and Women’s Hospital opracował probiotyk, który hamuje w mózgu autozapalne reakcje prowadzące do stwardnienia rozsianego.
W testach na zwierzętach nowa metoda okazała się skuteczniejsza i bezpieczniejsza od standardowych leków.
– Zmodyfikowane probiotyki mogą rewolucjonizować sposób leczenia chorób przewlekłych – mówi dr Francisco Quintana, główny autor badania opisanego w periodyku „Nature”. – Kiedy przyjmuje się zwykły lek, po spożyciu początkowej dawki jego stężenie we krwi osiąga szczyt, ale potem jego poziom spada. Jednakże, jeśli uda się wykorzystać żywe mikroorganizmy do produkcji leku wewnątrz organizmu, mogą one nieustannie wytwarzać aktywny związek w miarę potrzeb, co jest kluczowe w przypadku chorób przewlekłych wymagających stałego leczenia – wyjaśnia.
Jak podają badacze, w USA choroby autoimmunologiczne dotykają od 5 do 8 proc. populacji. W większości przypadków opcje terapeutyczne są przy tym mocno ograniczone. Schorzenia dotykające mózg, takie jak stwardnienie rozsiane, są szczególnie trudne w leczeniu, ponieważ wiele leków nie pokonuje tzw. bariery krew-mózg i nie dociera w miejsce potencjalnego działania.
Autorzy nowego badania skupili się na tzw. komórkach dendrytycznych licznie występujących zarówno w układzie pokarmowym, jak i w okolicach mózgu. Biorą one udział w kontrolowaniu pracy układu odpornościowego.
Badacze odkryli mechanizm, z pomocą którego wspomniane komórki powstrzymują inne komórki odpornościowe przed atakowaniem własnego organizmu.
– Odkryty przez nas mechanizm to jakby hamulec dla układu immunologicznego. U większości ludzi jest aktywny, ale u osób z chorobami autoimmunologicznymi są z nim problemy. Organizm nie może wtedy chronić się przed własnym układem odpornościowym – wyjaśnia dr Quintana.
On i jego zespół zauważyli, że mechanizm ten można uaktywnić z pomocą mleczanu – związku ważnego dla różnych procesów metabolicznych. Potem badacze zmodyfikowali genetycznie bakterie tak, aby wytwarzały mleczan.
– Probiotyki to nic nowego – wszyscy widzimy je sprzedawane jako suplementy i promowane jako sposób na poprawę zdrowia. Korzystając z metod biologii syntetycznej, stworzyliśmy probiotyczne bakterie wytwarzające specyficzne, ważne dla choroby cząsteczki. Możemy więc wykorzystać zalety probiotyków, rozwinąć je do maksimum – wyjaśnia dr Quintana.
W testach na myszach z chorobą odpowiadającą ludzkiemu stwardnieniu rozsianemu dało się zauważyć wyraźną poprawę w mózgach zwierząt, mimo że bakterie żyły tylko w ich jelitach.
– W ostatnich dekadach odkryliśmy, że bakterie jelitowe silnie oddziałują na ośrodkowy układ nerwowy. Jednym z powodów, dla którego skupiliśmy się na stwardnieniu rozsianym była chęć sprawdzenia, czy uda się wykorzystać ten efekt do terapii autoimmunologicznych chorób mózgu. Wyniki sugerują, że tak – mówi specjalista.
Zdaniem naukowców ich metodę można będzie szybko przetestować u ludzi, ponieważ wykorzystany szczep bakterii już się ludziom podaje. Pracują także nad terapiami autoimmunologicznych chorób atakujących inne części ciała, w tym zespołu jelita drażliwego. I zakładają firmę w celu komercjalizacji wynalazku.
– Zdolność wykorzystania żywych komórek jako źródła leków w organizmie niesie ogromny potencjał w tworzeniu bardziej spersonalizowanych i precyzyjnych terapii – twierdzi dr Quintana. –Jeśli te mikroby żyjące w jelitach są wystarczająco potężne, by wpływać na stan zapalny w mózgu, jesteśmy pewni, że będziemy w stanie wykorzystać ich moc również w innych miejscach – dodaje.
Zobacz zdjęcia: Ważenie przed galą Strife Tube w Lublinie
Polecany artykuł: